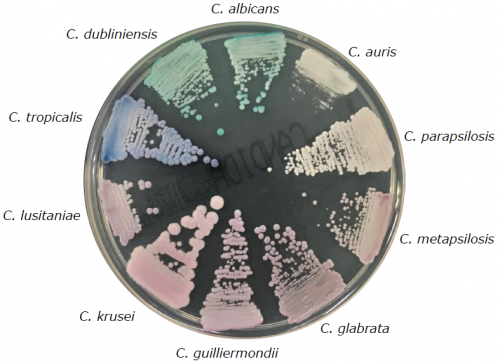

產品介紹
CHROMagar 科瑪嘉 酵素基質呈色培養基
臨床病原菌彩色培養基
科瑪嘉 CHROMagar Candida
 |
產品說明:
科瑪嘉 CHROMagar Candida 培養基
用來分離和鑑別臨床主要常見念珠菌屬
微生物典型生長外觀:
白色念珠菌→綠色菌落
熱帶念珠菌→金屬藍色菌落
克魯斯念珠菌→粉色、毛絨狀菌落
其他→白色到淡紫色
|
| 產品名稱 : 科瑪嘉 CHROMagar Candida |
| ► |
微生物典型生長外觀
|
| ► |
培養基使用特點 |
| |
1.顏色高度對比:明顯的菌落呈色使菌種鑑別更容易。
2.需再35 °C 下培養36-48小時。
3.全面性的判讀結果:可同時一次判讀檢體中含有的主要和次要的念珠菌菌種。
4.高準度的篩選:此培養基可以高度專一與敏感的同時展現出三種念珠菌菌種。
Candida albicans -> 準確度達99%
Candida tropicalis ->準確度達99%
Candida krusei ->準確度達99%
*.準確度數據來自相關科學文獻:” CHROMagar Candida, a new differential isolation medium for the presumptive identification of clinically important Candida species” Odds F. et al 1994, Journal of Clinical Microbiology, 32 : 1923-1929.
5.減少工作負荷:傳統的Sabouraud培養基難以鑑別不同的菌種,而科瑪嘉CHROMagar Candida培養基可以只用菌落顏色就可以即時鑑別各種念珠菌菌種。
6.可協助病人進行適當的抗真菌治療方式。 |
►培養基配方

| Gain flexibility using powder rather than ready to use plates: Use the entire pack, or if there is a need for a smaller number of plates, just a portion. If kept under appropriate storage temperature, CHROMagarTM Candida has a 3 years shelf of life. This flexibility is essential to avoid the waste resulting from expired-unused plates. No need of supplements: all components are included in the powder. |

Please refer to our IFU and Material Safety data sheet for complete information about the medium. CHROMagar™, Rambach™, AquaCHROM™ are trademarks created by Dr. A. Rambach.
Last Update: 26-Oct-2017 |
| ► |
專門培養念珠菌 |
| |
共生酵母通常存在於人的口腔,胃腸道,陰道和皮膚中,念珠菌也可能是機緣性病原體。 它們是真菌感染的最常見原因之一。
主要有兩種主要疾病(稱為念珠菌病或念珠菌病):
-皮膚粘膜念珠菌病:通常,這些後果很輕微,但是在免疫功能低下的患者(如HIV陽性患者)中,這些皮膚或粘膜感染會變得很嚴重。
-系統性念珠菌病:由於免疫抑制,大手術,創傷等導致感染抵抗力急劇下降的患者發生感染。
|
| ► |
念珠菌流行病學問題 |
| |
由於藥物治療的進展以及患者抵抗力的下降和易感宿主數量的增加,1990年代以來念珠菌感染的血液發生率有所上升,但近年來一直穩定存在。
更常見的是,念珠菌屬涉及淺表口咽和泌尿生殖道感染。 T“及早診斷對於患者的早期有效治療至關重要。”《世界衛生組織關於機會性感染HIV的實驗室診斷標準操作程序指南》
儘管白色念珠菌仍是主要的物種,但由於新的抗真菌劑非常有效地對抗白色念珠菌,其他種類如熱帶念珠菌(C. tropicalis),克魯斯念珠菌(C. krusei)或光滑念珠菌(C.glabrata)也按比例增加。 |
參考文獻 http://www.chromagar.com/fichiers/1411739032ijsrp_p2775_1_.pdf
http://www.chromagar.com/fichiers/14114834846963.pdf
http://www.chromagar.com/fichiers/1255695447PFALLER_JCM_96_CA.pdf

|
| 有興趣請點選 |
 |
參觀選購 |
|
|